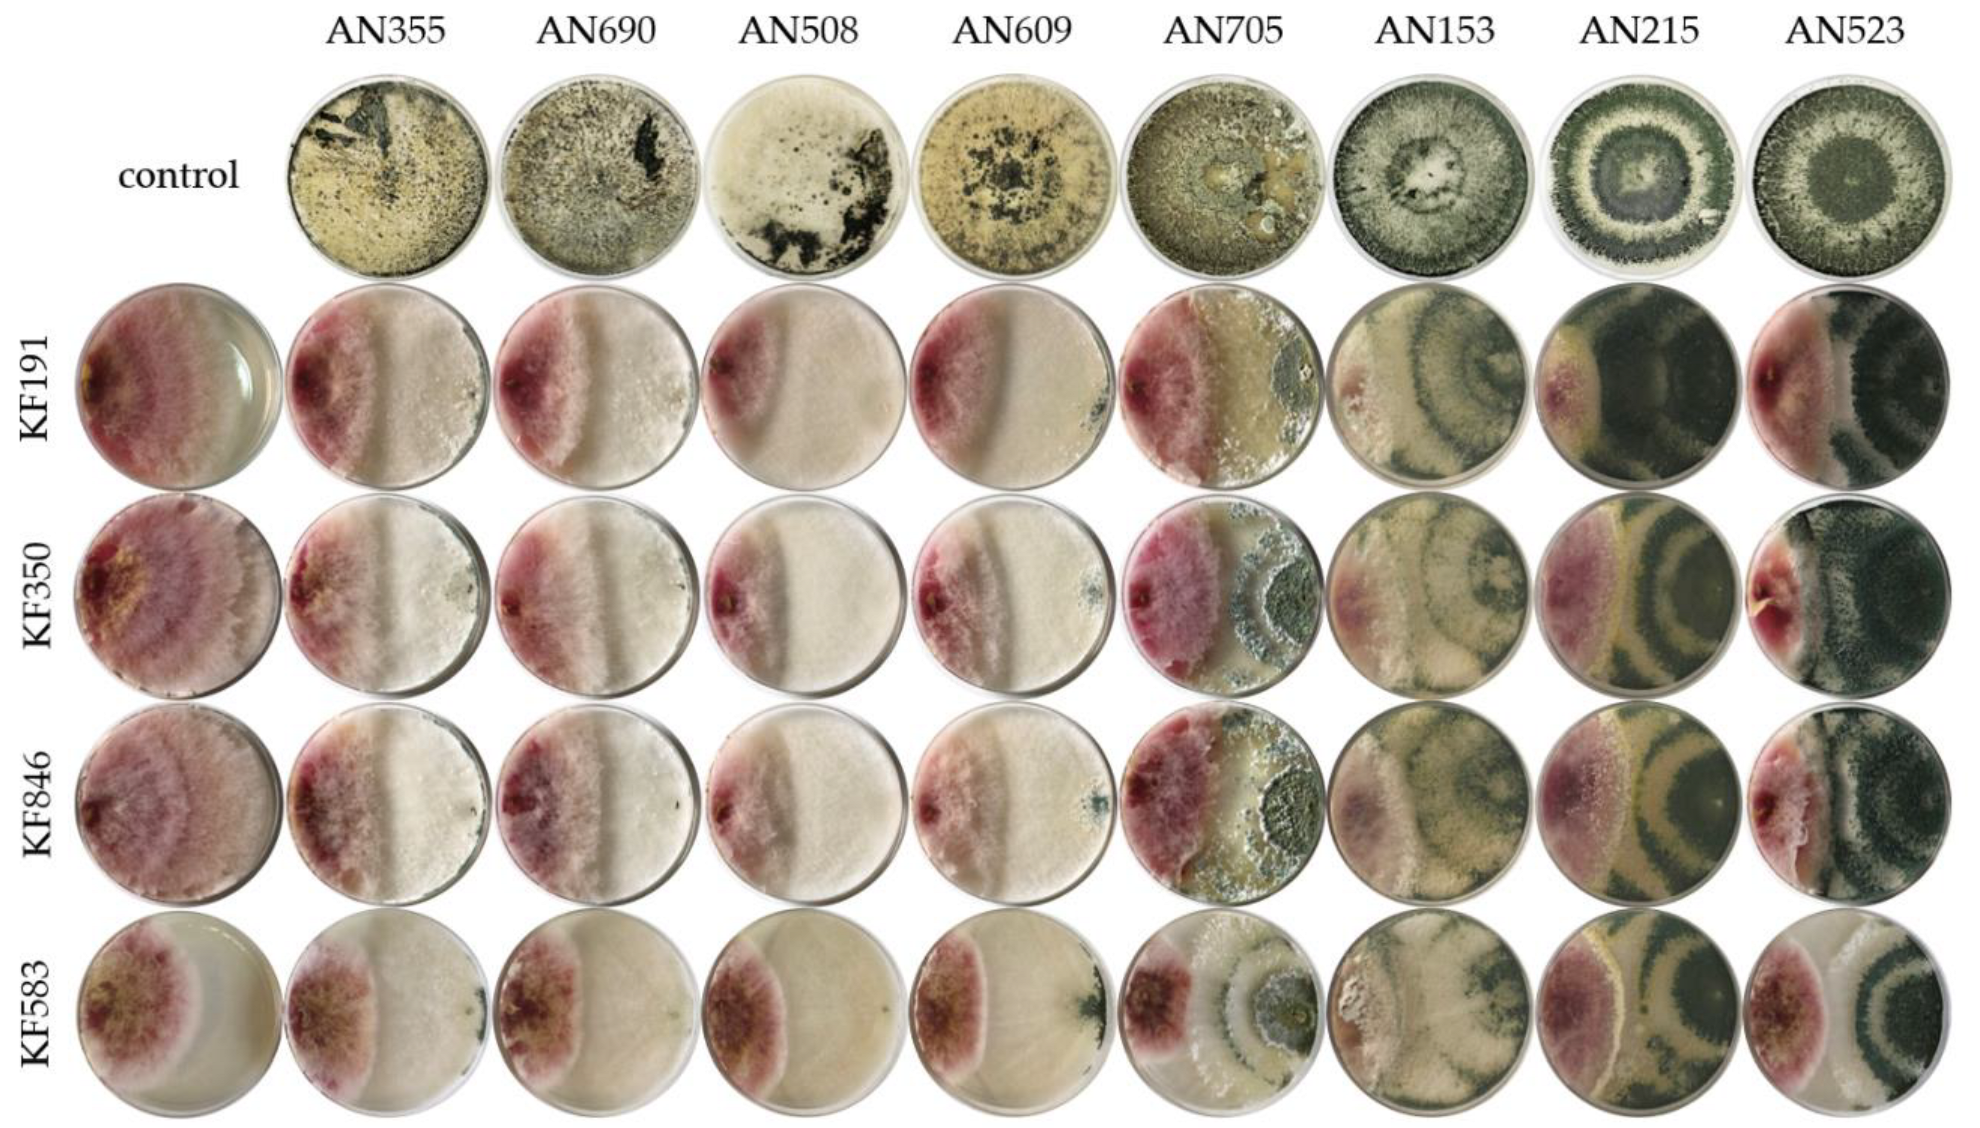
Molecules 27 08146 g001 Molecules 27 08146 g001

Trichoderma versus Fusarium—Inhibition of Pathogen Growth and Mycotoxin Biosynthesis
Abstract
1. Introduction
2. Results
2.1. Evaluation of the Antagonistic Potential of Trichoderma Fungi
2.2. The Effect of Trichoderma on Mycotoxin Biosynthesis by Fusarium spp.
3. Discussion
3.1. Antagonistic Properties
3.2. Biosynthesis Inhibition of Fusarium Toxins by Trichoderma Species
4. Materials and Methods
4.1. Chemicals and Reagents
4.2. Fungal Isolates
4.3. Dual Culture Bioassay
4.4. Determination of the Mycotoxin Biosynthesis Inhibition
4.5. Sample Preparation
4.6. UHPLC-HESI-MS/MS
4.7. Statistical Analysis
4.8. Method Validation
5. Conclusions
Supplementary Materials
Author Contributions
Funding
Institutional Review Board Statement
Informed Consent Statement
Data Availability Statement
Conflicts of Interest
Sample Availability
References
- Chatterjee, S.; Kuang, Y.; Splivallo, R.; Chatterjee, P.; Karlovsky, P. Interactions among filamentous fungi Aspergillus niger, Fusarium verticillioides and Clonostachys rosea: Fungal biomass, diversity of secreted metabolites and fumonisin production. BMC Microbiol. 2016, 16, 83. [Google Scholar] [CrossRef]
- Parveen, G.; Urooj, F.; Moin, S.; Farhat, H.; Fahim, M.F.; Ehteshamul-Haque, S. Estimation of losses caused by root rotting fungi and root knot nematodes infecting some important crops in lower sindh and hub, balochistan of Pakistan. Pak. J. Bot. 2020, 52, 673–678. [Google Scholar] [CrossRef]
- Peng, Y.; Li, S.J.; Yan, J.; Tang, Y.; Cheng, J.P.; Gao, A.J.; Yao, X.; Ruan, J.J.; Xu, B.L. Research progress on phytopathogenic fungi and their role as biocontrol agents. Front. Microbiol. 2021, 12, 670135. [Google Scholar] [CrossRef]
- Różewicz, M.; Wyzińska, M.; Grabiński, J. The most important fungal diseases of cereals—Problems and possible solutions. Agronomy 2021, 11, 714. [Google Scholar] [CrossRef]
- Miedaner, T.; Boeven, A.L.G.C.; Gaikpa, D.S.; Kistner, M.B.; Grote, C.P. Genomics-assisted breeding for quantitative disease resistances in small-grain cereals and maize. Int. J. Mol. Sci. 2020, 21, 9717. [Google Scholar] [CrossRef]
- Mannaa, M.; Kim, K.D. Influence of temperature and water activity on deleterious fungi and mycotoxin production during grain storage. Mycobiology 2017, 45, 240–254. [Google Scholar] [CrossRef] [PubMed]
- Palacios, S.A.; Del Canto, A.; Erazo, J.; Torres, A.M. Fusarium cerealis causing Fusarium head blight of durum wheat and its associated mycotoxins. Int. J. Food Microbiol. 2021, 346, 109161. [Google Scholar] [CrossRef]
- Bryła, M.; Stępniewska, S.; Modrzewska, M.; Waśkiewicz, A.; Podolska, G.; Ksieniewicz-Woźniak, E.; Yoshinari, T.; Stepień, Ł.; Urbaniak, M.; Roszko, M.; et al. Dynamics of deoxynivalenol and nivalenol glucosylation in wheat cultivars infected with Fusarium culmorum in field conditions—A 3 year study (2018–2020). J. Agric. Food Chem. 2022, 70, 4291–4302. [Google Scholar] [CrossRef] [PubMed]
- Schiwek, S.; Alhussein, M.; Rodemann, C.; Budragchaa, T.; Beule, L.; von Tiedemann, A.; Karlovsky, P. Fusarium culmorum produces NX-2 toxin simultaneously with deoxynivalenol and 3-acetyl-deoxynivalenol or nivalenol. Toxins 2022, 14, 456. [Google Scholar] [CrossRef]
- Gerez, J.R.; Pinton, P.; Callu, P.; Grosjean, F.; Oswald, I.P.; Bracarense, A.P.F. Deoxynivalenol alone or in combination with nivalenol and zearalenone induce systemic histological changes in pigs. Exp. Toxicol. Pathol. 2015, 67, 89–98. [Google Scholar] [CrossRef] [PubMed]
- Abdel-Wahhab, M.A.; El-Nekeety, A.A.; Salman, A.S.; Abdel-Aziem, S.H.; Mehaya, F.M.; Hassan, N.S. Protective capabilities of silymarin and inulin nanoparticles against hepatic oxidative stress, genotoxicity and cytotoxicity of deoxynivalenol in rats. Toxicon 2018, 142, 1–13. [Google Scholar] [CrossRef]
- Lu, P.S.; Wang, Y.; Jiao, L.; Sun, S.C. Nivalenol affects Cyclin B1 level and activates SAC for cell cycle progression in mouse oocyte meiosis. Cell Prolif. 2022, 55, e13277. [Google Scholar] [CrossRef]
- Ropejko, K.; Twarużek, M. Zearalenone and its metabolites—General overview, occurrence, and toxicity. Toxins 2021, 13, 35. [Google Scholar] [CrossRef] [PubMed]
- Köhl, J.; Kolnaar, R.; Ravensberg, W.J. Mode of action of microbial biological control agents against plant diseases: Relevance beyond efficacy. Front. Plant Sci. 2019, 10, 845. [Google Scholar] [CrossRef] [PubMed]
- Kuchheuser, P.; Birringer, M. Pesticide residues in food in the European Union: Analysis of notifications in the European Rapid Alert System for Food and Feed from 2002 to 2020. Food Control 2022, 133, 108575. [Google Scholar] [CrossRef]
- Barzman, M.; Lamichhane, J.R.; Booij, K.; Boonekamp, P.; Desneux, N.; Huber, L.; Messean, A. Research and development priorities in the face of climate change and rapidly evolving pests. Sustain. Agric. Res. 2015, 17, 1–27. [Google Scholar] [CrossRef]
- Azizbekyan, R.R. Biological preparations for the protection of agricultural plants. Appl. Biochem. Microbiol. 2019, 55, 816–823. [Google Scholar] [CrossRef]
- Nayak, N.; Sar, K.; Sahoo, B.K.; Mahapatra, P. Beneficial effect of effective microorganism on crop and soil—A review. Res. Rev. J. Pharmacogn. Phytochem. 2020, 9, 3070–3074. [Google Scholar]
- Rai, S.; Kashyap, P.L.; Kumar, S.; Srivastava, A.K.; Ramteke, P.W. Comparative analysis of microsatellites in five different antagonistic Trichoderma species for diversity assessment. World J. Microbiol. Biotechnol. 2016, 32, 8. [Google Scholar] [CrossRef]
- Zehra, A.; Dubey, M.K.; Meena, M.; Upadhyay, R.S. Effect of different environmental conditions on growth and sporulation of some Trichoderma species. J. Environ. Biol. 2017, 38, 197. [Google Scholar] [CrossRef]
- Longa, C.M.O.; Pertot, I.; Tosi, S. Ecophysiological requirements and survival of a Trichoderma atroviride isolate with biocontrol potential. J. Basic Microbiol. 2008, 48, 269–277. [Google Scholar] [CrossRef]
- Zeilinger, S.; Gruber, S.; Bansal, R.; Mukherjee, P.K. Secondary metabolism in Trichoderma—Chemistry meets genomics. Fungal Biol. Rev. 2016, 30, 74–90. [Google Scholar] [CrossRef]
- López-Bucio, J.; Pelagio-Flores, R.; Herrera-Estrella, A. Trichoderma as biostimulant: Exploiting the multilevel properties of a plant beneficial fungus. Sci. Hortic. 2015, 196, 109–123. [Google Scholar] [CrossRef]
- Tian, Y.; Zhang, D.; Cai, P.; Lin, H.; Ying, H.; Hu, Q.N.; Wu, A. Elimination of Fusarium mycotoxin deoxynivalenol (DON) via microbial and enzymatic strategies: Current status and future perspectives. Trends Food Sci Technol. 2022, 124, 96–107. [Google Scholar] [CrossRef]
- Dini, I.; Alborino, V.; Lanzuise, S.; Lombardi, N.; Marra, R.; Balestrieri, A.; Ritieni, A.; Woo, S.; Vinale, F. Trichoderma enzymes for degradation of aflatoxin B1 and ochratoxin A. Molecules 2022, 27, 3959. [Google Scholar] [CrossRef]
- Tian, Y.; Yu, D.; Liu, N.; Tang, Y.; Yan, Z.; Wu, A. Confrontation assays and mycotoxin treatment reveal antagonistic activities of Trichoderma and the fate of Fusarium mycotoxins in microbial interaction. Environ. Pollut. 2020, 267, 115559. [Google Scholar] [CrossRef]
- Modrzewska, M.; Bryła, M.; Kanabus, J.; Pierzgalski, A. Trichoderma as a biostimulator and biocontrol agent against Fusarium in the production of cereal crops: Opportunities and possibilities. Plant Pathol. 2022, 71, 1471–1485. [Google Scholar] [CrossRef]
- Mukherjee, P.K.; Mendoza-Mendoza, A.; Zeilinger, S.; Horwitz, B.A. Mycoparasitism as a mechanism of Trichoderma-mediated suppression of plant diseases. Fungal Biol. Rev. 2022, 39, 15–33. [Google Scholar] [CrossRef]
- Rajani, P.; Rajasekaran, C.; Vasanthakumari, M.M.; Olsson, S.B.; Ravikanth, G.; Shaanker, R.U. Inhibition of plant pathogenic fungi by endophytic Trichoderma spp. through mycoparasitism and volatile organic compounds. Microbiol. Res. 2021, 242, 126595. [Google Scholar] [CrossRef]
- Hewedy, O.A.; Abdel-Lateif, K.S.; Bakr, R.A. Genetic diversity and biocontrol efficacy of indigenous Trichoderma isolates against Fusarium wilt of pepper. J. Basic Microbiol. 2020, 60, 126–135. [Google Scholar] [CrossRef]
- Błaszczyk, L.; Basińska-Barczak, A.; Ćwiek-Kupczyńska, H.; Gromadzka, K.; Popiel, D. Stępień, Ł. Suppressive effect of Trichoderma spp. on toxigenic Fusarium species. Pol. J. Microbiol. 2017, 66, 85. [Google Scholar] [CrossRef] [PubMed]
- Larran, S.; Santamarina Siurana, M.P.; Roselló Caselles, J.; Simón, M.R.; Perelló, A. In vitro antagonistic activity of Trichoderma harzianum against Fusarium sudanense causing seedling blight and seed rot on wheat. ACS Omega 2020, 5, 23276–23283. [Google Scholar] [CrossRef] [PubMed]
- Xue, A.G.; Guo, W.; Chen, Y.; Siddiqui, I.; Marchand, G.; Liu, J.; Ren, C. Effect of seed treatment with novel strains of Trichoderma spp. on establishment and yield of spring wheat. Crop Prot. 2017, 96, 97–102. [Google Scholar] [CrossRef]
- Veenstra, A.; Rafudeen, M.S.; Murray, S.L. Trichoderma asperellum isolated from African maize seed directly inhibits Fusarium verticillioides growth in vitro. Eur. J. Plant Pathol. 2019, 153, 279–283. [Google Scholar] [CrossRef]
- Perincherry, L.; Łalak-Kańczugowska, J.; Stępień, Ł. Fusarium-Produced mycotoxins in plant-Pathogen interactions. Toxins 2019, 11, 664. [Google Scholar] [CrossRef] [PubMed]
- Mironenka, J.; Różalska, S.; Bernat, P. Potential of Trichoderma harzianum and its metabolites to protect wheat seedlings against Fusarium culmorum and 2, 4-D. Int. J. Mol. Sci. 2021, 22, 13058. [Google Scholar] [CrossRef]
- Sallam, N.; Eraky, A.M.; Sallam, A. Effect of Trichoderma spp. on Fusarium wilt disease of tomato. Mol. Biol. Rep. 2019, 46, 4463–4470. [Google Scholar] [CrossRef]
- Halifu, S.; Deng, X.; Song, X.; Song, R.; Liang, X. Inhibitory mechanism of Trichoderma virens ZT05 on Rhizoctonia solani. Plants 2020, 9, 912. [Google Scholar] [CrossRef] [PubMed]
- Matarese, F.; Sarrocco, S.; Gruber, S.; Seidl-Seiboth, V.; Vannacci, G. Biocontrol of Fusarium head blight: Interactions between Trichoderma and mycotoxigenic Fusarium. Microbiology 2012, 158, 98–106. [Google Scholar] [CrossRef]
- Tian, Y.; Tan, Y.; Yan, Z.; Liao, Y.; Chen, J.; De Boevre, M.; De Saeger, S.; Wu, A. Antagonistic and detoxification potentials of Trichoderma isolates for control of zearalenone (ZEN) producing Fusarium graminearum. Front. Microbiol. 2018, 8, 2710. [Google Scholar] [CrossRef]
- Voigt, C.A.; von Scheidt, B.; Gacser, A.; Kassner, H.; Lieberei, R.; Schäfer, W.; Salomon, S. Enhanced mycotoxin production of a lipase-deficient Fusarium graminearum mutant correlates to toxin-related gene expression. Eur. J. Plant Pathol. 2007, 117, 1–12. [Google Scholar] [CrossRef]
- Mironenka, J.; Różalska, S.; Soboń, A.; Bernat, P. Trichoderma harzianum metabolites disturb Fusarium culmorum metabolism: Metabolomic and proteomic studies. Microbiol. Res. 2021, 249, 126770. [Google Scholar] [CrossRef]
- Ksieniewicz-Woźniak, E.; Bryła, M.; Michałowska, D.; Waśkiewicz, A.; Yoshinari, T. Transformation of selected Fusarium toxins and their masked forms during malting of various cultivars of wheat. Toxins 2021, 13, 866. [Google Scholar] [CrossRef] [PubMed]
- Tian, Y.; Tan, Y.; Liu, N.; Yan, Z.; Liao, Y.; Chen, J.; De Saeger, S.; Yang, H.; Zhang, Q.; Wu, A. Detoxification of deoxynivalenol via glycosylation represents novel insights on antagonistic activities of Trichoderma when confronted with Fusarium graminearum. Toxins 2016, 8, 335. [Google Scholar] [CrossRef]
- Yoshinari, T.; Sakuda, S.; Furihata, K.; Furusawa, H.; Ohnishi, T.; Sugita-Konishi, Y.; Ishizaki, N.; Terajima, J. Structural determination of a nivalenol glucoside and development of an analytical method for the simultaneous determination of nivalenol and deoxynivalenol, and their glucosides, in wheat. J. Agric. Food Chem. 2014, 62, 1174–1180. [Google Scholar] [CrossRef] [PubMed]
- Mańka, K. Fungal communities as criterion for estimating the effect of the environment of plant disease in Poland. Zesz. Probl. Postęp. Nauk Rol. 1974, 160, 9–23. [Google Scholar]
- Uwineza, P.A.; Urbaniak, M.; Bryła, M.; Stepien, Ł.; Modrzewska, M.; Waśkiewicz, A. In vitro effects of lemon balm extracts in reducing the growth and mycotoxins biosynthesis of Fusarium culmorum and F. proliferatum. Toxins 2022, 14, 355. [Google Scholar] [CrossRef]

| Pathogen/ Antagonist | F. culmorum KF191 | F. culmorum KF350 | F. culmorum KF846 | F. cerealis KF583 | Average | |
|---|---|---|---|---|---|---|
| T. viride | AN355 | 45.8 * ± 2.4 | 32.7 * ± 1.9 | 30.0 * ± 2.0 | 23.9 ± 2.1 | 33.1 ± 9.2 |
| AN690 | 53.6 * ± 2.4 | 42.3 * ± 9.6 | 48.0 * ± 2.0 | 45.1 * ± 2.1 | 47.3 ± 4.9 | |
| T. viridescens | AN508 | 49.0 * ± 3.9 | 31.4 * ± 7.8 | 28.0 * ± 7.2 | 50.0 * ± 15.0 | 39.6 ± 11.5 |
| AN609 | 51.6 * ± 1.6 | 42.3 * ± 3.8 | 36.0 * ± 2.0 | 42.3 * ± 5.3 | 43.0 ± 6.4 | |
| T. atroviride | AN705 | 56.8 * ± 3.9 | 42.9 * ± 2.9 | 59.3 * ± 5.0 | 49.3 * ± 7.6 | 52.1 ± 7.4 |
| AN153 | 45.3 * ± 1.6 | 39.1 * ± 5.6 | 50.0 * ± 2.0 | 57.7 * ± 4.2 | 48.0 ± 7.9 | |
| AN215 | 63.0 * ± 3.3 | 59.6 * ± 1.9 | 50.0 * ± 2.0 | 42.3 * ± 5.3 | 53.7 ± 9.4 | |
| AN523 | 65.6 * ± 4.1 | 49.4 * ± 6.2 | 42.7 * ± 6.4 | 42.3 * ± 5.3 | 50.0 ± 10.9 | |
| Pathogen/ Antagonist | F. culmorum KF191 | F. culmorum KF350 | F. culmorum KF846 | F. cerealis KF583 | Average * | |
|---|---|---|---|---|---|---|
| T. viride | AN355 | 8 | 4 | 4 | 4 | 5.0 |
| AN690 | 8 | 4 | 4 | 6 | 5.5 | |
| T. viridescens | AN508 | 8 | 4 | 6 | 6 | 6.0 |
| AN609 | 8 | 6 | 6 | 6 | 6.5 | |
| T. atroviride | AN705 | 8 | 6 | 4 | 6 | 6.0 |
| AN153 | 8 | 6 | 6 | 6 | 6.5 | |
| AN215 | 8 | 6 | 6 | 6 | 6.5 | |
| AN523 | 8 | 6 | 8 | 6 | 7.0 | |
| Strain | Mycotoxin [mg/kg] | ||||||||
|---|---|---|---|---|---|---|---|---|---|
| DON | DON3G | 3- + 15-AcDON | NIV | FUS-X | ZEN | ZEN-14S | α-ZOL | β-ZOL | |
| F. culmorum KF191 | |||||||||
| KF191 control | <LOQ | <LOQ | 23.95 a ± 3.89 | <LOQ | <LOQ | 47.36 a ± 8.69 | 3608 a ± 185 | 0.50 a ± 0.10 | 1.28 a ± 0.23 |
| KF191 vs. AN355 | <LOQ | <LOQ | 2.85 b ± 0.93 (↓88%) | <LOQ | <LOQ | 8.44 b ±1.64 (↓82%) | 90.78 b ± 14.10 (↓97%) | 0.18 b ± 0.04 (↓64%) | 1.05 a ± 0.06 (↓18%) |
| KF191 vs. AN690 | <LOQ | <LOQ | 0.18 b ±0.02 (↓99%) | <LOQ | <LOQ | 4.2 b ± 0.31 (↓91%) | 19.62 b ± 4.36 (↓99%) | <LOQ b (↓100%) | 0.41 b ± 0.11 (↓68%) |
| KF191 vs. AN508 | <LOQ | <LOQ | 0.43 b ± 0.09 (↓98%) | <LOQ | <LOQ | 1.69 b ± 0.22 (↓96%) | 10.53 b ± 2.85 (↓99%) | <LOQ b (↓100%) | 0.20 b ± 0.08 (↓84%) |
| KF191 vs. AN609 | <LOQ | <LOQ | 0.4 b ±0.14 (↓98%) | <LOQ | <LOQ | 0.56 b ± 0.05 (↓99%) | 1.78 b ± 0.65 (↓99%) | <LOQ b (↓100%) | 0.07 b ± 0.02 (↓94%) |
| KF191 vs. AN705 | <LOQ | <LOQ | 1.68 b ± 0.61 (↓93%) | <LOQ | <LOQ | 1.97 b ± 0.21 (↓96%) | 2.89 b ± 0.61 (↓99%) | <LOQ b (↓100%) | 0.30 b ± 0.01 (↓76%) |
| KF191 vs. AN153 | <LOQ | <LOQ | 0.11 b ± 0.01 (↓99%) | <LOQ | <LOQ | 0.99 b ± 0.17 (↓98%) | 13.06 b ± 2.35 (↓99%) | <LOQ b (↓100%) | 0.22 b ± 0.02 (↓83%) |
| KF191 vs. AN215 | <LOQ | <LOQ | <LOQ b (↓100%) | <LOQ | <LOQ | 2.75 b ± 0.49 (↓94%) | 52.51 b ± 9.65 (↓98%) | <LOQ b (↓100%) | 0.17 b ± 0.02 (↓84%) |
| KF191 vs. AN523 | <LOQ | <LOQ | 0.14 b ± 0.03 (↓99%) | <LOQ | <LOQ | 28.21 b ± 9.73 (↓40%) | 85.91 b ± 20.09 (↓97%) | <LOQ b (↓100%) | 0.69 b ± 0.21 (↓46%) |
| F. culmorum KF350 | |||||||||
| KF350 control | <LOQ | <LOQ | <LOQ | 15.83 a ± 5.14 | 86.86 a ± 21.90 | 12.20 a ± 3.21 | 641.68 a ± 165 | 0.28 a ± 0.05 | 0.62 a ± 0.11 |
| KF350 vs. AN355 | <LOQ | <LOQ | <LOQ | 2.01 b ± 0.54 (↓87%) | 5.18 b ± 0.91 (↓94%) | 7.59 b ± 1.70 (↓38%) | 33.15 b ± 10.10 (↓95%) | 0.22 a ± 0.05 (↓21%) | 1.09 b ± 0.38 (↑75%) |
| KF350 vs. AN690 | <LOQ | <LOQ | <LOQ | 0.58 b ± 0.21 (↓96%) | 0.55 b ± 0.11 (↓99%) | 2.34 b ± 0.58 (↓81%) | 35.23 b ± 15.53 (↓95%) | <LOQ (↓100%) | 0.21 b ± 0.06 (↓66%) |
| KF350 vs. AN508 | <LOQ | <LOQ | <LOQ | 1.41 b ± 0.10 (↓91%) | 0.41 b ± 0.05 (↓99%) | 1.97 b ± 0.17 (↓84%) | 52.78 b ± 6.27 (↓92%) | <LOQ (↓100%) | 0.40 a ± 0.14 (↓35%) |
| KF350 vs. AN609 | <LOQ | <LOQ | <LOQ | 1.13 b ± 0.47 (↓93%) | 0.78 b ± 0.25 (↓99%) | 10.75 a ± 3.86 (↓12%) | 17.31 b ± 4.89 (↓97%) | <LOQ (↓100%) | 0.36 a ± 0.17 (↓42%) |
| KF350 vs. AN705 | <LOQ | <LOQ | <LOQ | 1.42 b ± 0.06 (↓91%) | 3.19 b ± 1.24 (↓96%) | 6.98 b ± 1.74 (↓43%) | 31.13 b ± 6.39 (↓95%) | <LOQ (↓100%) | 0.30 a ± 0.07 (↓52%) |
| KF350 vs. AN153 | <LOQ | <LOQ | <LOQ | <LOQ b (↓100%) | 0.48 b ± 0.19 (↓99%) | 1.85 b ± 0.02 (↓85%) | 123.38 b ± 11.18 (↓80%) | <LOQ (↓100%) | 0.74 a ± 0.16 (↑19%) |
| KF350 vs. AN215 | <LOQ | <LOQ | <LOQ | <LOQ b (↓100%) | 0.13 b ± 0.04 (↓99%) | 0.25 b ± 0.12 (↓98%) | 22.01 b ± 8.31 (↓98%) | <LOQ (↓100%) | <LOQ b (↓100%) |
| KF350 vs. AN523 | <LOQ | <LOQ | <LOQ | 0.31 b ± 0.03 (↓98%) | 0.54 b ± 0.07 (↓99%) | 0.73 b ± 0.08 (↓94%) | 57.61 b ± 13.94 (↓91%) | <LOQ (↓100%) | <LOQ b (↓100%) |
| F. culmorum 846 | |||||||||
| KF846 control | 82.53 a ± 14.96 | <LOQ a | 111.09 a ± 33.53 | <LOQ | <LOQ | 164.29 a ± 16.77 | 2714 a± 572 | 2.17 a ± 0.25 | 2.77 a ± 0.28 |
| KF846 vs. AN355 | 12.29 b ± 1.00 (↓85%) | 0.86 b ± 0.15 | 1.94 b ± 0.22 (↓98%) | <LOQ | <LOQ | 64.33 b ± 5.96 (↓61%) | 76.56 b ± 20.77 (↓97%) | 1.09 b ± 0.42 (↓49%) | 4.60 b ± 1.57 (↑66%) |
| KF846 vs. AN690 | 22.34 b ± 3.77 (↓73%) | 2.43 b ± 0.21 | 3.26 b ± 0.90 (↓97%) | <LOQ | <LOQ | 58.56 b ± 14.95 (↓64%) | 49.20 b ± 6.84 (↓98%) | 0.58 b ± 0.17 (↓73%) | 2.42 a ± 0.91 (↓12%) |
| KF846 vs. AN508 | 18.40 b ± 1.13 (↓78%) | 1.28 b ± 0.26 | 8.14 b ± 1.77 (↓92%) | <LOQ | <LOQ | 40.56 b ± 11.57 (↓75%) | 37.31 b ± 1.37 (↓98%) | 0.68 b ± 0.25 (↓68%) | 1.15 b ± 0.49 (↓58%) |
| KF846 vs. AN609 | 5.11 b ± 1.33 (↓94%) | 1.55 b ± 0.48 | 0.81 b ± 0.19 (↓99%) | <LOQ | <LOQ | 54.46 b ± 9.70 (↓67%) | 46.04 b ± 6.17 (↓98%) | 0.52 b ± 0.08 (↓76%) | 1.56 a ± 0.14 (↓44%) |
| KF846 vs. AN705 | 6.21 b ± 0.49 (↓92%) | 0.69 b ± 0.16 | 3.32 b ± 0.28 (↓97%) | <LOQ | <LOQ | 104.30 b ± 16.69 (↓37%) | 52.75 b ± 10.76 (↓98%) | 0.33 b ± 0.05 (↓85%) | 1.31 b ± 0.12 (↓53%) |
| KF846 vs. AN153 | 2.21 b ± 0.15 (↓97%) | 1.41 b ± 0.34 | 1.64 b ± 0.23 (↓98%) | <LOQ | <LOQ | 12.14 b ± 1.23 (↓93%) | 13.89 b ± 2.19 (↓99%) | <LOQ b (↓100%) | 0.42 b ± 0.09 (↓85%) |
| KF846 vs. AN215 | 1.90 b ± 0.60 (↓98%) | <LOQ a | 1.93 b ± 0.48 (↓98%) | <LOQ | <LOQ | 6.89 b ± 2.28 (↓96%) | 44.37 b ± 3.92 (↓98%) | <LOQ b (↓100%) | 0.26 b ± 0.10 (↓91%) |
| KF846 vs. AN523 | 3.01 b ± 0.36 (↓96%) | <LOQ a | 0.38 b ± 0.03 (↓99%) | <LOQ | <LOQ | 21.55 b ± 4.08 (↓87%) | 24.83 b ± 5.64 (↓99%) | <LOQ b (↓100%) | 0.29 b ± 0.05 (↓89%) |
| F. cerealis 583 | |||||||||
| KF583 control | <LOQ | <LOQ | <LOQ | 24.07 a ± 9.42 | 119.70 a ± 44.26 | 238.63 a ± 38.66 | 9337 a ± 1146 | <LOQ | 6.63 a ± 1.56 |
| KF583 vs. AN355 | <LOQ | <LOQ | <LOQ | 0.84 b ± 0.29 (↓96%) | 11.70 b ± 4.55 (↓90%) | 2.20b ± 0.62 (↓99%) | 4.20 b ± 0.72 (↓99%) | <LOQ | 0.70 b ± 0.16 (↓89%) |
| KF583 vs. AN690 | <LOQ | <LOQ | <LOQ | 0.17 b ± 0.03 (↓99%) | 11.98 b ± 0.82 (↓90%) | 1.09 b ± 0.26 (↓99%) | 3.41 b ± 0.34 (↓99%) | <LOQ | <LOQ b (↓100%) |
| KF583 vs. AN508 | <LOQ | <LOQ | <LOQ | 0.25 b ± 0.07 (↓98%) | 1.54 b ± 0.07 (↓98%) | 0.54 b ± 0.09 (↓99%) | 1.31 b ± 0.47 (↓99%) | <LOQ | <LOQ b (↓100%) |
| KF583 vs. AN609 | <LOQ | <LOQ | <LOQ | 0.17 b ± 0.07 (↓99%) | 0.87 b ± 0.03 (↓99%) | 0.31 b ± 0.12 (↓99%) | 0.67 b ± 0.11 (↓99%) | <LOQ | 0.83 b ± 0.19 (↓87%) |
| KF583 vs. AN705 | <LOQ | <LOQ | <LOQ | 0.83 b ± 0.11 (↓96%) | 9.84 b ± 0.76 (↓91%) | 15.86 b ± 3.39 (↓93%) | 9.70 b ± 1.34 (↓99%) | <LOQ | 0.30 b ± 0.06 (↓95%) |
| KF583 vs. AN153 | <LOQ | <LOQ | <LOQ | <LOQ b (↓100%) | <LOQ b (↓100%) | 0.37 b ± 0.08 (↓99%) | 1.50 b ± 0.38 (↓99%) | <LOQ | <LOQ b (↓100%) |
| KF583 vs. AN215 | <LOQ | <LOQ | <LOQ | <LOQ b (↓100%) | <LOQ b (↓100%) | 1.52 b ± 0.54 (↓99%) | 7.14 b ± 0.57 (↓99%) | <LOQ | <LOQ b (↓100%) |
| KF583 vs. AN523 | <LOQ | <LOQ | <LOQ | <LOQ b (↓100%) | 0.31 b ± 0.11 (↓99%) | 0.37 b ± 0.05 (↓99%) | 1.62 b ± 0.34 (↓99%) | <LOQ | 0.08 b ± 0.02 (↓98%) |
Publisher’s Note: MDPI stays neutral with regard to jurisdictional claims in published maps and institutional affiliations. |
© 2022 by the authors. Licensee MDPI, Basel, Switzerland. This article is an open access article distributed under the terms and conditions of the Creative Commons Attribution (CC BY) license (https://creativecommons.org/licenses/by/4.0/).
Share and Cite
Modrzewska, M.; Błaszczyk, L.; Stępień, Ł.; Urbaniak, M.; Waśkiewicz, A.; Yoshinari, T.; Bryła, M. Trichoderma versus Fusarium—Inhibition of Pathogen Growth and Mycotoxin Biosynthesis. Molecules 2022, 27, 8146. https://doi.org/10.3390/molecules27238146
Modrzewska M, Błaszczyk L, Stępień Ł, Urbaniak M, Waśkiewicz A, Yoshinari T, Bryła M. Trichoderma versus Fusarium—Inhibition of Pathogen Growth and Mycotoxin Biosynthesis. Molecules. 2022; 27(23):8146. https://doi.org/10.3390/molecules27238146
Chicago/Turabian StyleModrzewska, Marta, Lidia Błaszczyk, Łukasz Stępień, Monika Urbaniak, Agnieszka Waśkiewicz, Tomoya Yoshinari, and Marcin Bryła. 2022. "Trichoderma versus Fusarium—Inhibition of Pathogen Growth and Mycotoxin Biosynthesis" Molecules 27, no. 23: 8146. https://doi.org/10.3390/molecules27238146
APA StyleModrzewska, M., Błaszczyk, L., Stępień, Ł., Urbaniak, M., Waśkiewicz, A., Yoshinari, T., & Bryła, M. (2022). Trichoderma versus Fusarium—Inhibition of Pathogen Growth and Mycotoxin Biosynthesis. Molecules, 27(23), 8146. https://doi.org/10.3390/molecules27238146

